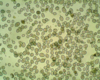

Pictures midterm 1 Flashcards

Nagana - T.vivax, T.congolense, T. brucei brucei

Trypanosoma in blood smear

Leishmania amastigotes

Leishmania promastigotes

Leishmania amastigotes

Leishmania promastigote

Giardia unstained

Giardia cysts

Giardia trophozoites

Giardia cysts (lugol solution)

Trichomonas

living trichomonas

Trichomonosis of birds - Trichomonas gallinae

Trichomonas gallinae

Histomonosis

Histomonas meleagridis PAS staining

Oocyst of eimeria spp.

Smear of intestinal mucosa with Oocyst of Eimeria, stained with Giemsa

Macrogamonts and oocysts of Eimeria

Fecal smear with Eimeria Oocysts stained w Kinyou staining

Smear of Eimeria Oocysts stained with Iodine

Fecal smear w Eimeria oocyst, stained with Kionyoun

Gametogony of Eimeria tenella in caecum of chicken

Schizogony of Eimeria tenella in caecum of chicken